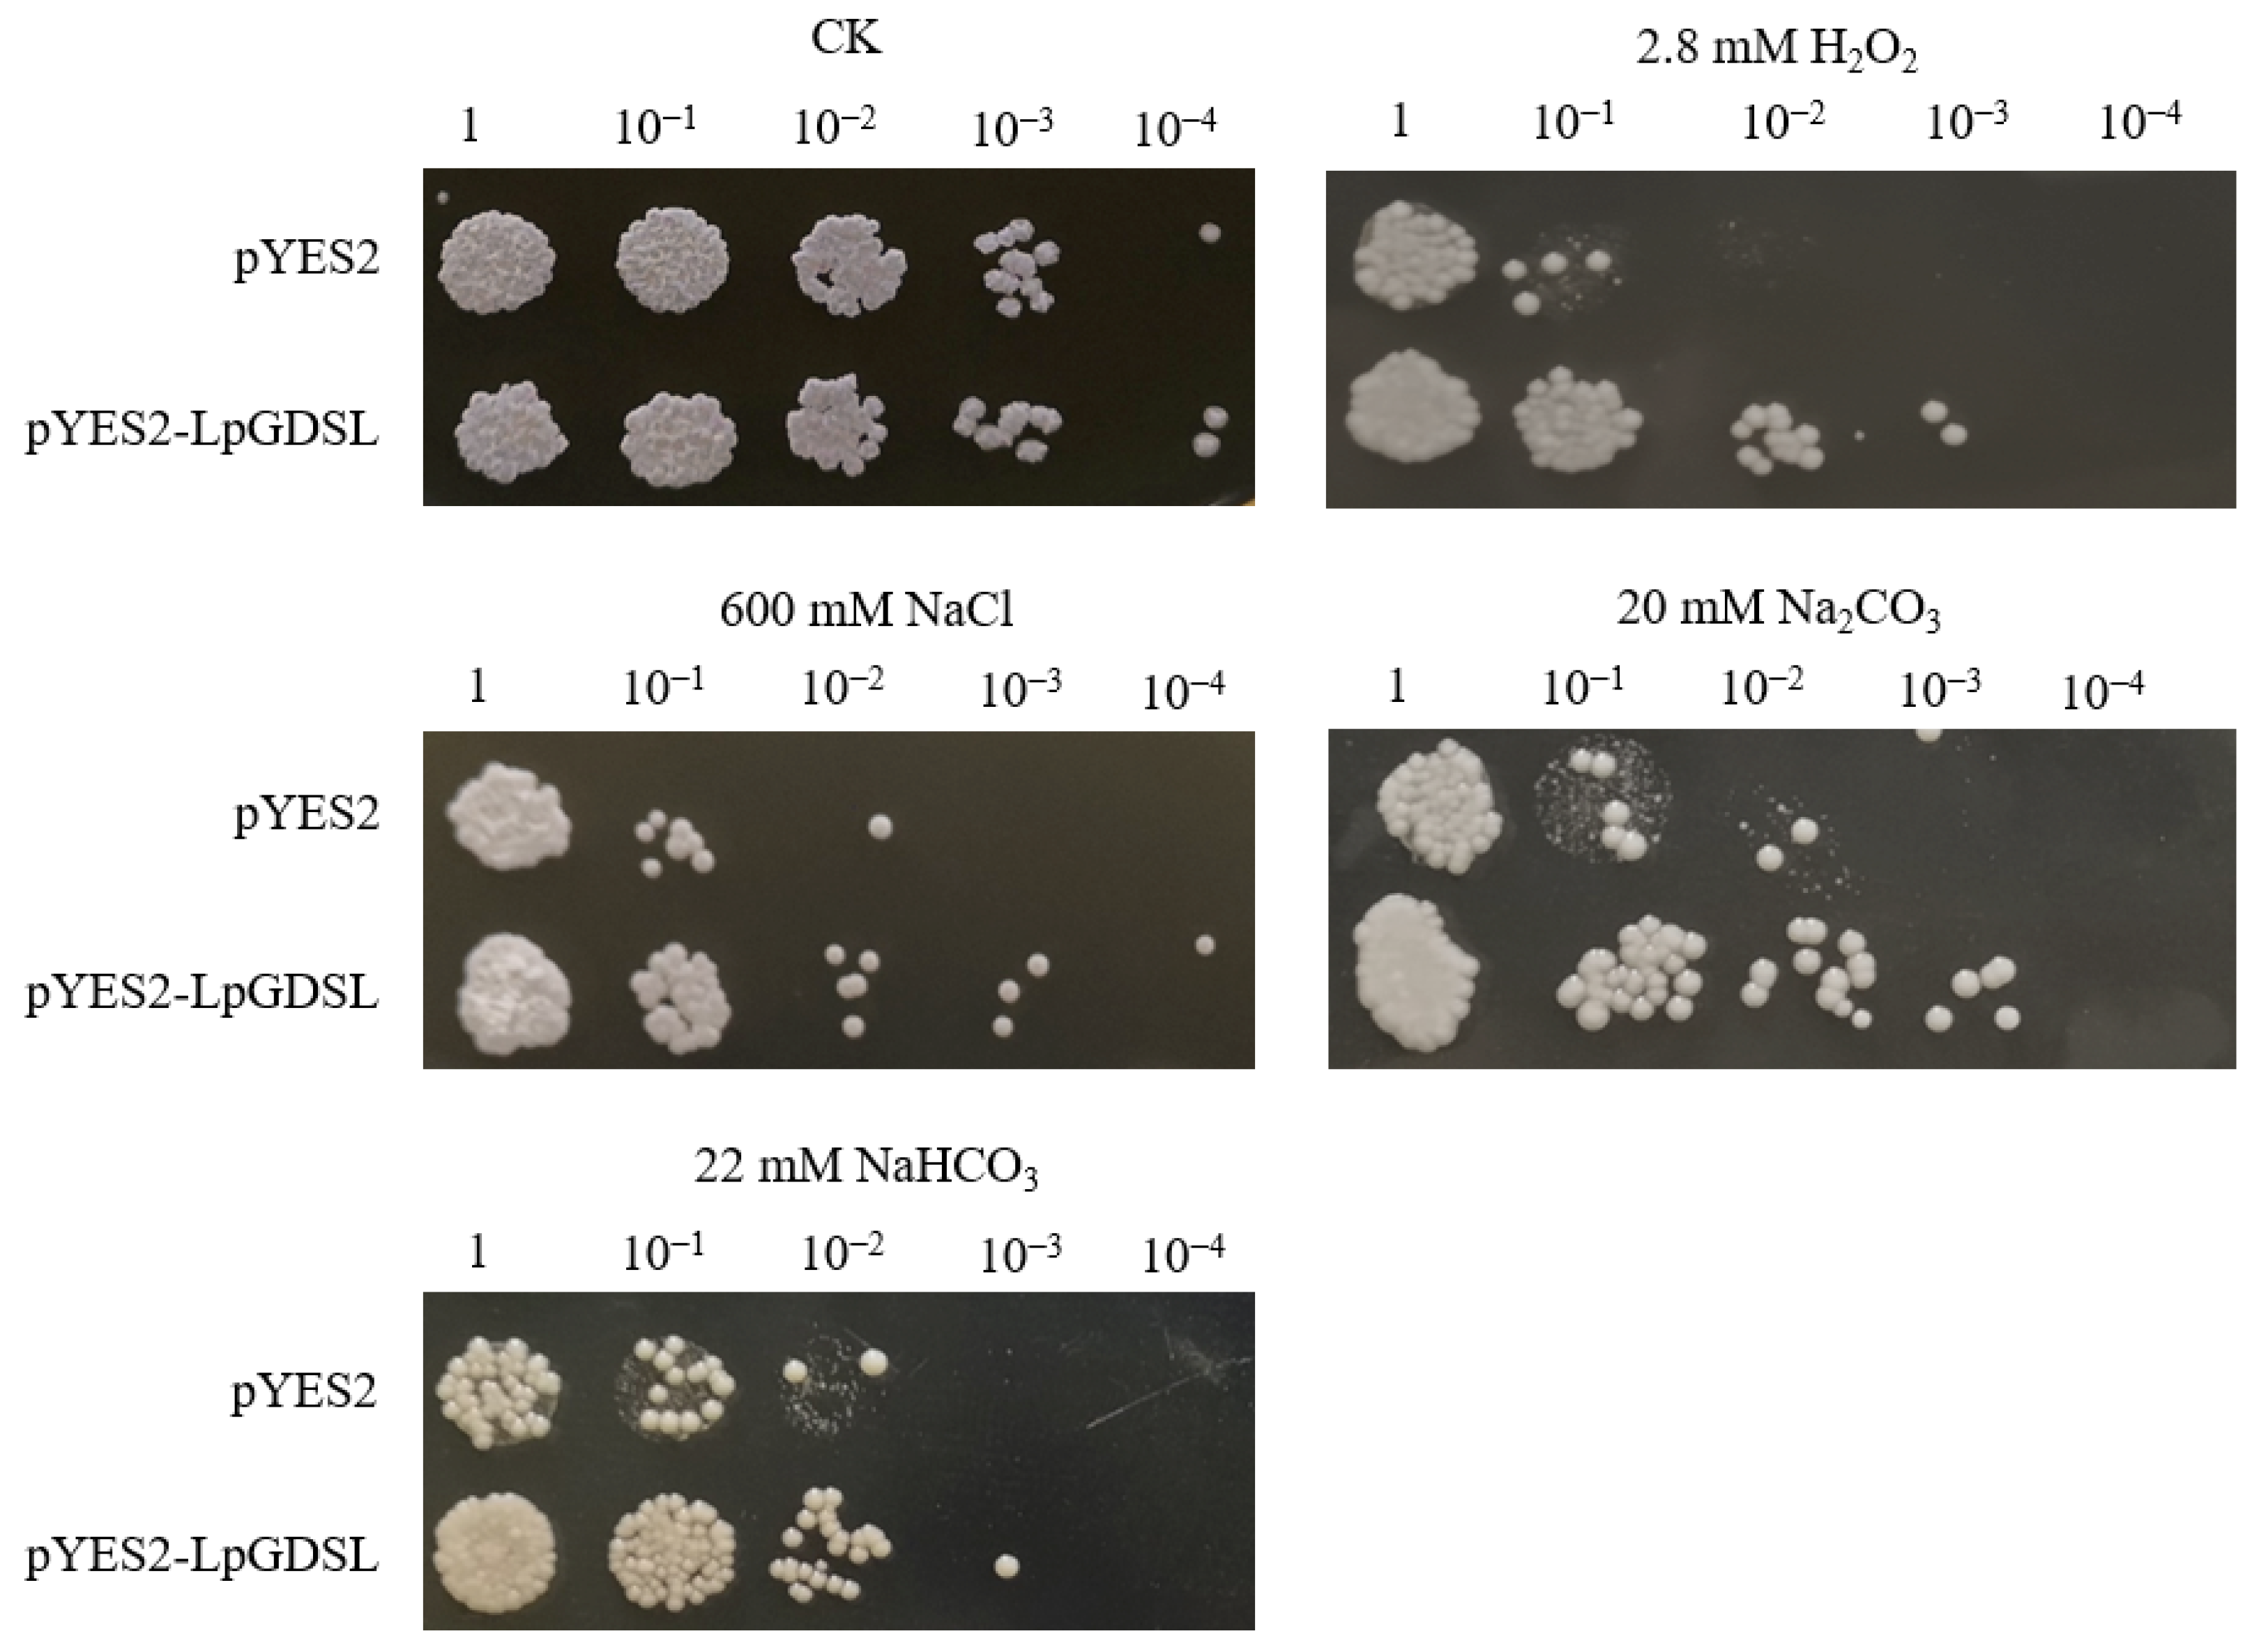
Ijms 25 09319 g003

GDSL in Lilium pumilum (LpGDSL) Confers Saline–Alkali Resistance to the Plant by Enhancing the Lignin Content and Balancing the ROS
Abstract
1. Introduction
2. Results
2.1. Cloning and Bioinformatics Analysis of LpGDSL Gene
2.2. mRNA Expression Specificity Analysis and Yeast Resistance Analysis
2.3. LpGDSL Protein Induced Expression and Purification
2.4. Resistance Analysis of LpGDSL Overexpression in L. pumilum
2.5. Yeast Two-Hybrid Screening Interacting Proteins
2.6. Promoter Cloning and Analysis
3. Discussion
4. Materials and Methods
4.1. Plant Materials and Growing Conditions
4.2. Gene Cloning and Bioinformatics Analysis
4.3. LpGDSL mRNA Level Expression Specificity Analysis
4.4. Yeast Resistance Analysis
4.5. LpGDSL Protein-Induced Expression and Purification
4.6. Acquisition and Resistance Analysis of Overexpressed Plants
4.7. Screening and Validation of LpGDSL-Interacting Proteins by Yeast Two-Hybrid
4.8. Validation of LpGDSL-Interacting Proteins by BiFC
4.9. Promoter Cloning
4.10. B3 Regulation of the LpGDSL Promoter Validated by Dual-Luciferase Reporter
4.11. B3 Regulation of the LpGDSL Promoter Validated by Yeast One-Hybrid
4.12. Statistical Analysis
5. Conclusions
Supplementary Materials
Author Contributions
Funding
Institutional Review Board Statement
Informed Consent Statement
Data Availability Statement
Acknowledgments
Conflicts of Interest
References
- Hao, K. Research on Genetic Diversity of Wild Lilium pumlium DC Germplasm Resources in Yan’an Area; Yan’an University: Yan’an, China, 2017. [Google Scholar]
- Brick, D.J.; Brumlik, M.J.; Buckley, J.T.; Cao, J.-X.; Davies, P.C.; Misra, S.; Tranbarger, T.J.; Upton, C. A new family of lipolytic plant enzymes with members in rice, arabidopsis and maize. FEBS Lett. 1995, 377, 475–480. [Google Scholar]
- Jiao, Y.; Zhang, J.; Pan, C. Genome-wide analysis of the GDSL genes in pecan (Carya illinoensis k. koch): Phylogeny, structure, promoter cis-elements, co-expression networks, and response to salt stresses. Genes 2022, 13, 1103. [Google Scholar] [CrossRef]
- Fang, L.Q.; Shang, H.Y.; Duan, Z.Z.; Yao, W.; Gong, J.B.; Huang, J.X.; Xu, J.S.; Zhang, M.Q. Appraisal and analysis on transcriptome-based sugarcane GELP gene family. Mol. Plant Breed. 2022, 1–19. [Google Scholar]
- Mo, S.J.; Wang, Z.C.; Wang, X.F.; Liu, Z.W.; Wu, L.Q.; Zhang, G.Y.; Ma, Z.Y.; Zhang, Y.; Duan, H.J. Genome-wide identification of GELP family genes in cotton and expression analysis under stress. J. Agric. Sci. Technol. 2022, 24, 93–103. [Google Scholar]
- Yan, X.; Fan, B.; Zhang, X.; Yu, Z.; Fang, Y.; Wu, J.; Zhao, Y.; Ma, Y. Sequence and expression analysis of GDSL esterase/lipase gene in agropyron mongolicum. J. China Agric. Univ. 2023, 28, 41–56. [Google Scholar]
- Liu, Y.H. Cloning and Preliminary Functional Analysis of GDSL Lipase Gene CpGLIP1 Promoter in Chimonanthus praecox (L.); Southwest University: Chongqing, China, 2024. [Google Scholar]
- Zhang, M. Cloning and Functional Analysis of a Rice Blast Resistance Gene BRG8; Chinese Academy of Agricultural Sciences: Beijing, China, 2019. [Google Scholar]
- Yu, H.; Zhang, X.; Ma, Y.; Li, M.; Chen, F.; Li, S.; Guo, S.; Zhang, Y. Sequence analysis of GDSL esterase/lipase genes in Helianthus annuus L. J. China Agric. Univ. 2018, 23, 18–28. [Google Scholar]
- Mao, Q.; Wang, S. Brief analysis on the trend of improve saline alkali soil in China. Hubei Agric. Sci. 2020, 59 (Suppl. S1), 302–306. [Google Scholar]
- Chiconato, D.A.; de Santana Costa, M.G.; Balbuena, T.S.; Munns, R.; Dos Santos, D.M. Proteomic analysis of young sugarcane plants with contrasting salt tolerance. Funct. Plant Biol. 2021, 48, 588–596. [Google Scholar] [CrossRef]
- Hong, J.K.; Choi, H.W.; Hwang, I.S.; Kim, D.S.; Kim, N.H.; Choi, D.S.; Kim, Y.J.; Hwang, B.K. Function of a novel GDSL-type pepper lipase gene, CaGLIP1, in disease susceptibility and abiotic stress tolerance. Planta 2008, 227, 539–558. [Google Scholar] [CrossRef]
- Zhao, Z.; Liu, J.; Jia, R.; Bao, S.; Chen, X. Physiological and TMT-based proteomic analysis of oat early seedlings in response to alkali stress. J. Proteom. 2019, 193, 10–26. [Google Scholar] [CrossRef]
- Zhou, L.; Yang, M.; Li, R. Genome-wide identification and expression analysis of GDSL esterasr/lipase genes in Elaeis guineensis. Mol. Plant Breed. 2023, 21, 4545–4559. [Google Scholar]
- Zhan, X.; Qian, Y.; Mao, B. Identification of two GDSL-type esterase/lipase genes related to tissue-specific lipolysis in Dendrobium catenatum by multi-omics analysis. Life 2022, 12, 1563. [Google Scholar] [CrossRef]
- Arpigny, J.L.; Jaeger, K.-E. Bacterial lipolytic enzymes: Classification and properties. Biochem. J. 1999, 343, 177–183. [Google Scholar] [CrossRef] [PubMed]
- Jiang, Y.; Chen, R.; Dong, J.; Xu, Z.; Gao, X. Analysis of GDSL lipase (GLIP) family genes in rice (Oryza sativa). Plant Omics 2012, 5, 351–358. [Google Scholar]
- Pollard, M.; Beisson, F.; Li, Y.; Ohlrogge, J.B. Building lipid barriers: Biosynthesis of cutin and suberin. Trends Plant Sci. 2008, 13, 236–246. [Google Scholar] [CrossRef] [PubMed]
- Zhang, L.; Gao, C.; Mentink-Vigier, F.; Tang, L.; Zhang, D.; Wang, S.; Cao, S.; Xu, Z.; Liu, X.; Wang, T. Arabinosyl deacetylase modulates the arabinoxylan acetylation profile and secondary wall formation. Plant Cell 2019, 31, 1113–1126. [Google Scholar] [CrossRef]
- Yadav, V.K.; Yadav, V.K.; Pant, P.; Singh, S.P.; Maurya, R.; Sable, A.; Sawant, S.V. GhMYB1 regulates SCW stage-specific expression of the GhGDSL promoter in the fibres of Gossypium hirsutum L. Plant Biotechnol. J. 2017, 15, 1163–1174. [Google Scholar] [CrossRef]
- Chen, S. Preliminary Analysis on the Function of LpBCP and LpCPC Genes in Lilium pumilum; Northeast Forestry University: Harbin, China, 2021. [Google Scholar]
- Zhang, X.; Xue, H.; Khan, A.; Jia, P.; Kong, X.; Li, L.; Zhang, Z. Physio-biochemical and proteomic mechanisms of coronatine induced potassium stress tolerance in xylem sap of cotton. Ind. Crops Prod. 2021, 173, 114094. [Google Scholar] [CrossRef]
- Zhu, W.; Gao, E.; Shaban, M.; Wang, Y.; Wang, H.; Nie, X.; Zhu, L. GhUMC1, a blue copper-binding protein, regulates lignin synthesis and cotton immune response. Biochem. Biophys. Res. Commun. 2018, 504, 75–81. [Google Scholar] [CrossRef]
- Jin, S.; Wang, X.; Dong, Y.; Li, G.; Chang, X.; Zhang, L.; Jin, S. The gene LpBCP increased NaHCO3 resistance by enhancing lignin or ROS scavenging in the Nicotiana benthamiana. Plant Biol. 2022, 24, 1057–1065. [Google Scholar] [CrossRef]
- Luo, G.; Ye, L.; Chen, X. Research progress of Arabidopsis B3 transcription factor gene superfamily. Chem Life 2013, 33, 287–293. [Google Scholar]
- Li, L.; Qiu, M.; Dong, H.; Shen, H.; Song, S.; Wang, T.; Li, Y.; Zhang, L.; Li, L.; Wang, J. Analysis of bioinformatics and expression pattern of rice B3 transcription factor OsL1. Mol. Plant Breed. 2021, 19, 4880–4886. [Google Scholar]
- Tong, Z.; Zhang, Y.; Wang, L.; Li, A.; Wang, W.; Wang, P.; Liu, H.; Liu, Q.; Wang, C. Genome wide identification and expression pattern analysis of B3 gene family in maize. Pratacult. Sci. 2023, 40, 2556–2570. [Google Scholar]
- Lu, L.; Qanmber, G.; Li, J.; Pu, M.; Chen, G.; Li, S.; Liu, L.; Qin, W.; Ma, S.; Wang, Y. Identification and characterization of the ERF subfamily B3 group revealed GhERF13. 12 improves salt tolerance in upland cotton. Front. Plant Sci. 2021, 12, 705883. [Google Scholar] [PubMed]
- Wei, M.; Li, H.; Wang, Q.; Liu, R.; Yang, L.; Li, Q. Genome-wide identification and expression profiling of B3 transcription factor genes in Populus alba × Populus glandulosa. Front. Plant Sci. 2023, 14, 1193065. [Google Scholar] [CrossRef] [PubMed]
- Liu, B.; Liu, J.; Yu, J.; Wang, Z.; Sun, Y.; Li, S.; Lin, Y.-C.J.; Chiang, V.L.; Li, W.; Wang, J.P. Transcriptional reprogramming of xylem cell wall biosynthesis in tension wood. Plant Physiol. 2021, 186, 250–269. [Google Scholar] [CrossRef]
- Fang, H.; Zhai, Y.; Li, C. Evaluating the impact of soil erosion on soil quality in an agricultural land, northeastern China. Sci. Rep. 2024, 14, 15629. [Google Scholar] [CrossRef]
- Fang, Q.; Min, W.J.; Wang, H.; Fei, H.L.; Zhen, L.C.; Hui, W.B.; Huyi, H.; Qin, G.X. Comparison and analysis of the methods of RNA isolation for Dioscorea opposita Tbunb. Genom. Appl. Biol. 2009, 28, 755–759. [Google Scholar]
- Chen, S.; Xie, M.; Cui, M.; Li, W.; Xu, Z.; Jia, C.; Yang, G. Identification of Broussonetia papyrifera transcription Factor BpbZIP1 and analysis of its response to cadmium stress. Bull. Bot. Res. 2022, 42, 394. [Google Scholar]
- Chen, Y.; Fan, H.; Liu, Y.; Liang, K.; Lin, W.; Jia, Q. Prokaryotic expression, purification, and activity of the inositol polyphosphate 5-phosphatase Gs5PTase8 from wild soybean. Chin. J. Biotechnol. 2024, 1–17. [Google Scholar]
- Tang, X. Construction of Dehydrin-BDN1 Binary Expression Vector and Agrobacterium Mediated Leaf-Disk Tobacco Transformation; Capital Normal University: Beijing, China, 2002. [Google Scholar]
- Han, Y. Molecular Mechanism of Ubiquitin-Conjugating Enzyme OsUBC11 on Root Development of Rice; Northeast Institute of geography and Agroecology, Chinese Academy of Sciences: Changchun, China, 2023. [Google Scholar]
- Fu, Y.; Wei, Z.; Wang, Y.; Liu, X.; Wang, B.; Qiao, Y.; Li, G.; Zhang, K. Identification of Saline-Alkali Stress and Determination of Physiological Index of Wild Soybean (Glycine soja) in Eastern Hebei Province. J. Nucl. Agric. Sci. 2020, 34, 2316–2325. [Google Scholar]
- Xu, T.; Li, S.; Wang, H.; Dong, H.; Li, Q.; Liu, Y. Study on Growth and Physiological Characteristics of Peanut under Saline-alkali Stress. Acta Agric. Boreali-Occident. Sin. 2023; 32, 866–877. [Google Scholar]
- Qin, S.; Zhang, J.; Li, W. Transient Expression of GUS Gene in Phaeophytes Using Biolistic Particle Delivery System. Chin. Sci. Abstr. Ser. B 1995, 2, 61–62. [Google Scholar]
- Ge, Q. Cloning of the Choline Monooxygenase Gene of Salix Salina and Its Expression in Tobacco; Dalian University of Technology: Dalian, China, 2005. [Google Scholar]
- Feng, J.; Wang, Y.; Deng, Q.; Zhai, H.; Ye, X.; Wei, D.; Wang, Z.; Tang, Q. Expression of Brassica juncea BjuWRKY75 and its interactions with flowering integrator BjuFT. Chin. J. Biotechnol. 2022, 38, 3029–3040. [Google Scholar]

Disclaimer/Publisher’s Note: The statements, opinions and data contained in all publications are solely those of the individual author(s) and contributor(s) and not of MDPI and/or the editor(s). MDPI and/or the editor(s) disclaim responsibility for any injury to people or property resulting from any ideas, methods, instructions or products referred to in the content. |
© 2024 by the authors. Licensee MDPI, Basel, Switzerland. This article is an open access article distributed under the terms and conditions of the Creative Commons Attribution (CC BY) license (https://creativecommons.org/licenses/by/4.0/).
Share and Cite
Wang, Z.; Wan, W.; Shi, M.; Ji, S.; Zhang, L.; Wang, X.; Zhang, L.; Cui, H.; Liu, X.; Sun, H.; et al. GDSL in Lilium pumilum (LpGDSL) Confers Saline–Alkali Resistance to the Plant by Enhancing the Lignin Content and Balancing the ROS. Int. J. Mol. Sci. 2024, 25, 9319. https://doi.org/10.3390/ijms25179319
Wang Z, Wan W, Shi M, Ji S, Zhang L, Wang X, Zhang L, Cui H, Liu X, Sun H, et al. GDSL in Lilium pumilum (LpGDSL) Confers Saline–Alkali Resistance to the Plant by Enhancing the Lignin Content and Balancing the ROS. International Journal of Molecular Sciences. 2024; 25(17):9319. https://doi.org/10.3390/ijms25179319
Chicago/Turabian StyleWang, Zongying, Wenhao Wan, Miaoxin Shi, Shangwei Ji, Ling Zhang, Xiaolu Wang, Lingshu Zhang, Huitao Cui, Xingyu Liu, Hao Sun, and et al. 2024. "GDSL in Lilium pumilum (LpGDSL) Confers Saline–Alkali Resistance to the Plant by Enhancing the Lignin Content and Balancing the ROS" International Journal of Molecular Sciences 25, no. 17: 9319. https://doi.org/10.3390/ijms25179319
APA StyleWang, Z., Wan, W., Shi, M., Ji, S., Zhang, L., Wang, X., Zhang, L., Cui, H., Liu, X., Sun, H., Yang, F., & Jin, S. (2024). GDSL in Lilium pumilum (LpGDSL) Confers Saline–Alkali Resistance to the Plant by Enhancing the Lignin Content and Balancing the ROS. International Journal of Molecular Sciences, 25(17), 9319. https://doi.org/10.3390/ijms25179319

